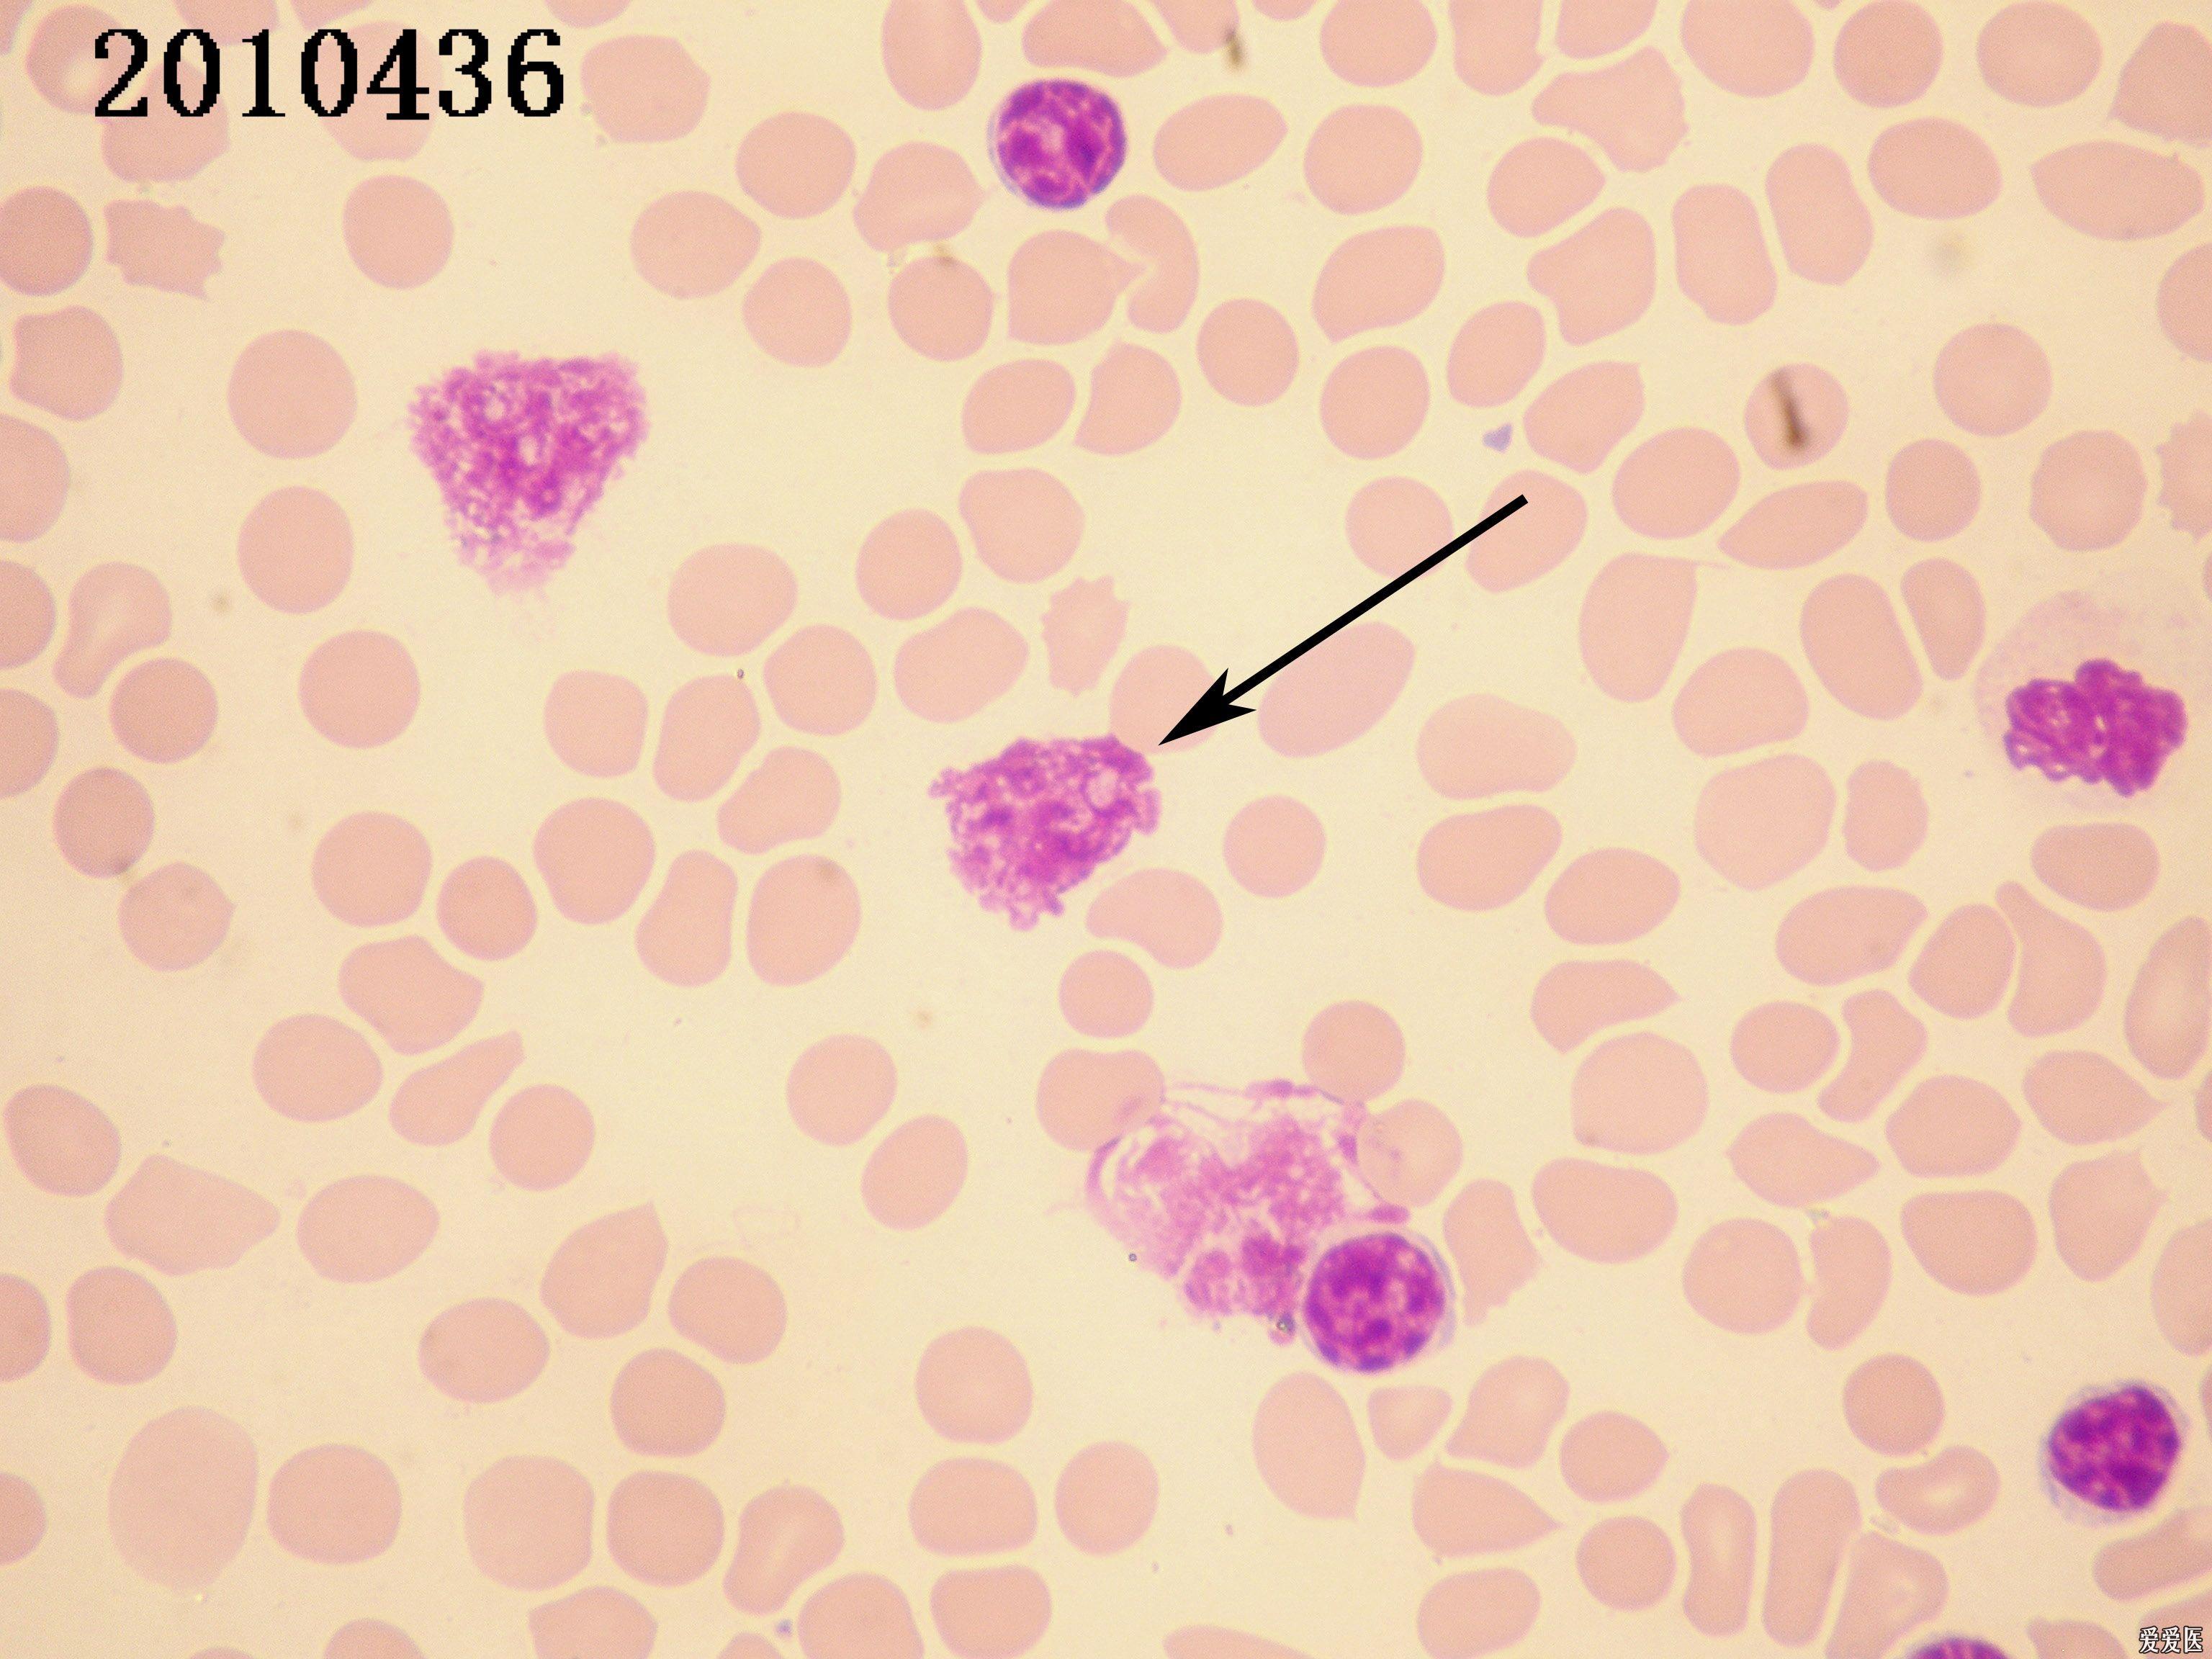
上海细胞形态学第二次室间质控 - 检验医学讨论版 - 爱爱医医学论坛

检验形态学

2021年第1次浙江省医院检验科体液形态学室间质量评价
图片尺寸947x743
第61期重庆市检验质控中心"金显微镜"形态学培训—璧山区检验质控中心
图片尺寸1199x1210
20171026南川区医学检验质控中心形态学答案
图片尺寸735x511
卫生部临床检验中心2015年尿液沉渣形态学检查室间质量评价
图片尺寸1002x741
第94期重庆市检验质控中心"金显微镜"形态学培训----黔江区质控中心
图片尺寸918x905
2021年第2次血细胞形态学检查室间质量评价_检验
图片尺寸1080x823
为你揭秘检验科细胞形态学检查
图片尺寸1000x537
临床基础检验形态学 龚道元 张时民 黄道连主编 本科检验
图片尺寸500x500
第61期重庆市检验质控中心"金显微镜"形态学培训—璧山区检验质控中心
图片尺寸1199x1199
第94期重庆市检验质控中心"金显微镜"形态学培训----黔江区质控中心
图片尺寸918x899
【检验】形态学图谱②Ⅱ白细胞形态学图谱
图片尺寸1013x1280
第90期重庆市检验质控中心"金显微镜"形态学-重庆市大足区人民医院
图片尺寸1280x960
实用临床医学检验形态学之正常血细胞形态学(实验)ppt
图片尺寸1080x810
秀山医学检验质量控制中心"金显微镜"形态学培训(第45期)
图片尺寸2000x2666
实用临床医学检验形态学之血液系统疾病与血细胞图谱
图片尺寸640x427
2019年第1次浙江省医院检验科体液形态学室间质量评价
图片尺寸713x537
上海细胞形态学第二次室间质控 - 检验医学讨论版 - 爱爱医医学论坛
图片尺寸3072x2304
血液学细胞形态
图片尺寸1080x845
湖南省临床检验中心2021年形态学检查室间质量评价第1次
图片尺寸1080x658
2021年第2次血细胞形态学检查室间质量评价_检验
图片尺寸1080x823